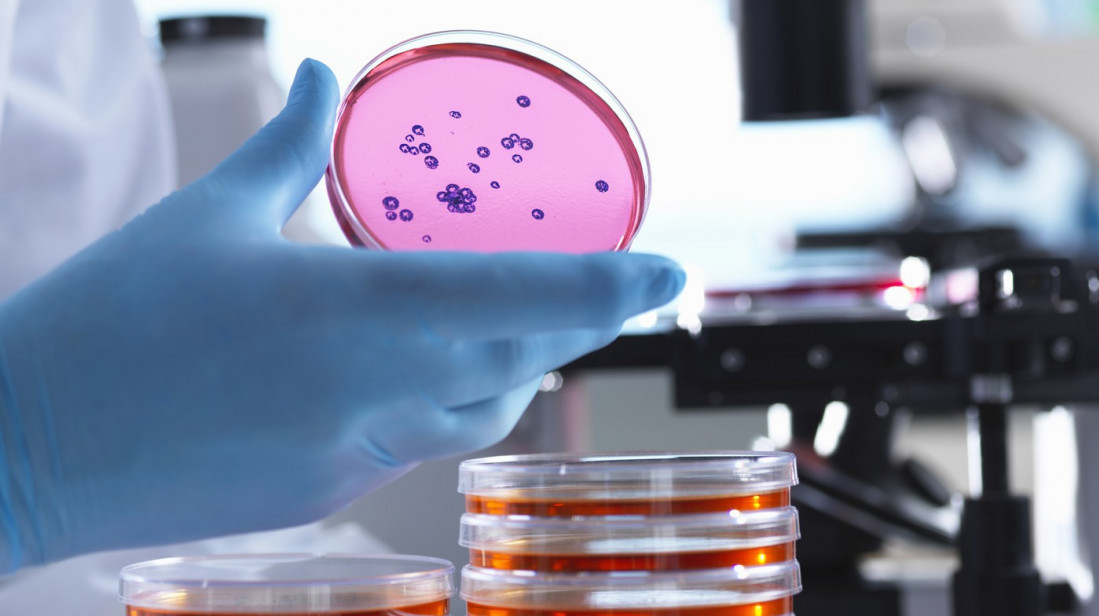

Severna Irska: U najvećem jezeru otkriveni geni sposobni da stvore superbakterije otporne na antibiotike
Komentari
Geni sposobni da stvore superbakterije otporne na antibiotike otkriveni su u najvećem jezeru u Ujedinjenom kraljevstvu koje snabdeva pijaćom vodom oko 40 odsto stanovništva u Severnoj Irskoj, piše danas Gardijan.
Prilikom testiranja vode iz jezera Loh Ni, koje ima površinu od skoro 400 kvadratnih kilometara, otkriveni su geni otporni na širok spektar antibiotika, uključujući karbapeneme, lekove rezervisane za infekcije opasne po život kada svi drugi tretmani ne uspeju.
Otkriće dolazi u trenutku kada broj smrtnih slučajeva povezanih sa infekcijama otpornim na antibiotike raste širom sveta, navodi list.
Skoro 400 rezistentnih infekcija se prijavljuje svake nedelje u Engleskoj, a broj smrtnih slučajeva povezanih sa njima dostigao je oko 2.379 u 2024. godini, pokazuju podaci britanske Agencije za zdravstvenu bezbednost.
Svetska zdravstvena organizacija (SZO) opisuje ovu antimikrobnu rezistenciju (AMR) kao "jedan od najhitnijih, najsloženijih i najstrašnijih zdravstvenih izazova našeg vremena".
"Karbapenemi su poznati kao antibiotici poslednje linije odbrane jer se koriste samo kada drugi tretmani nisu uspeli", rekao je profesor mikrobiologije na Univerzitetu u Ekseteru, Vil Gejz.
On je dodao da, ako su patogeni otporni na karbapenemske antibiotike, otporni su i na mnoge druge.
Uzorci iz područja određenog za kupanje na jezeru su takođe bili zagađeni.
"Ako bi plivač progutao 30 mililitara vode iz jezera, bio bi prilično dobro izložen genima otpornosti na karbapenem, ali ne znamo kakav to uticaj ima na crevni mikrobiom, ili rizik od infekcije", kazao je Gejz.
Pored gena otpornosti, u vodi su otkriveni markeri ljudskih, kravljih i svinjskih fekalija, navodi Gardijan.
Otpadne vode i stočni izmet stvaraju idealne uslove za superbakterije, ispirajući patogene, ostatke antibiotika i otporne bakterije u vodene tokove gde mogu da se mešaju, razmnožavaju i šire, upozoravaju stručnjaci.
profimedia
Zagađenje otpadnim vodama i fekalijama je široko rasprostranjeno širom Velike Britanije.
Uprkos raznim merama zaštite životne sredine, Loh Ni je sada u tako lošem stanju da su aktivisti nedavno održali "ceremoniju sahrane" za jezero.
Ministar poljoprivrede, životne sredine i ruralnih poslova Severne Irske, Endru Mjur, rekao je da se više od 20 miliona tona neprečišćenih otpadnih voda svake godine izliva u vodene tokove zemlje.
Čak i prečišćena kanalizacija predstavlja, međutim, rizik.
Profesor nauke o životnoj sredini i javnom zdravlju na Univerzitetu Bangor, Dejvi Džouns, upozorio je da samo zato što se otpadne vode prečišćavaju, ne znači da su bezbedne.
Fiskalni savet Severne Irske saopštio je, međutim, da kompanija nema dovoljno sredstava za obim ulaganja u otpadne vode koji je potreban i da je bila primorana da umesto toga da prioritet vodi za piće.
Zbog toga, Vodovod Severne Irske troši javni novac pokušavajući da očisti zagađenje koje je izazvala njihova sopstvena infrastruktura, navodi list.
Portparol Vodovodstva Severne Irske priznao je da decenijama nije dovoljno ulagano, rekavši da je kompanija ostala sa "veoma ograničenim prostorom za nadogradnje".
On je dodao da bi samo trajni, održivi investicioni plan zatvorio dugoročni jaz u finansiranju.
Viša saradnica u tink-tenk organizaciji Zelena alijansa, Rut Čembers, rekla je da situacija ima sve elemente da bude "savršena oluja" za zdravlje ljudi i životne sredine Severne Irske.
Ona je pozvala na ubrzano osnivanje nezavisne agencije za zaštitu životne sredine.
Savetnica za politiku u Kraljevskom društvu hemičara, Natali Sims, upozorila je da Velika Britanija rizikuje da zaostane za EU, koja uvodi zakone koji zahtevaju od zemalja da prate antimikrobnu rezistentnost u otpadnim vodama.
Svetska zdravstvena organizacija (SZO) upozorila je da bi, bez hitne akcije, infekcije otporne na lekove mogle da odnesu 39 miliona života širom sveta do 2050. godine i nametnu godišnji ekonomski teret u visini do 412 milijardi dolara.




















Komentari (0)